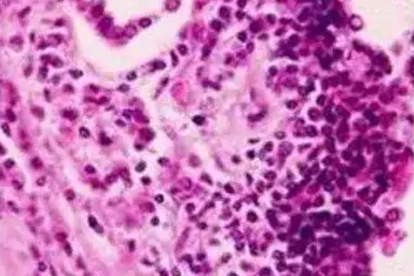

广州治疗肺癌比较好的医院有中山大学肿瘤防治中心、广东省人民医院、广州医科大学附属第一医院、南方医科大学南方医院、广州市胸科医院、中山大学附属第一医院、广州中医药大学第一附属医院、广东省中医院、广州市第一人民医院、广州医科大学附属肿瘤医院。
肺癌是一种常见的恶性肿瘤,其发病原因复杂,包括吸烟、空气污染、职业暴露等多种因素。早期诊断和规范治疗对提高患者生存率至关重要。
1.中山大学肿瘤防治中心-胸外科
中山大学肿瘤防治中心是国内知名的肿瘤专科医院,在肺癌诊疗方面具有丰富经验。医院拥有的诊断设备和多学科协作团队,能够为患者提准的个体化治疗方案。中心在肺癌微创手术、靶向治疗等领域处于国内水平。
中山大学肿瘤防治中心地址:广州市越秀区东风东路651号。
就诊科室:胸外科、肿瘤内科。
门诊时间:周一至周五上午8:00-12:00,下午14:30-17:30。
2.广东省人民医院-胸外科
广东省人民医院胸外科在肺癌诊治方面具有显著优势,年手术量位居华南地区前列。医院引进了达芬奇手术机器人系统,能够开展高难度的微创手术。同时,医院在肺癌综合治疗方面积累了丰富经验,形成了规范化的诊疗流程。
广东省人民医院地址:广州市越秀区中山二路106号。
就诊科室:胸外科、呼吸内科。
门诊时间:周一至周日全天开放。
3.广州医科大学附属第一医院-呼吸内科
广州医科大学附属第一医院呼吸内科是国家重点学科,在肺癌早期诊断和介入治疗方面具有独特优势。医院拥有华南地区大的呼吸疾病诊疗中心,开展支气管镜下诊疗、经皮肺穿刺等技术,为肺癌患者提供全方位服务。
广州医科大学附属第一医院地址:广州市越秀区沿江西路151号。
就诊科室:呼吸内科、胸外科。
门诊时间:周一至周五上午8:00-12:00,下午14:00-17:00。
4.南方医科大学南方医院-肿瘤科
南方医科大学南方医院肿瘤科在肺癌综合治疗方面具有丰富经验,建立了多学科会诊制度。医院拥有的放疗设备和专业的医疗团队,能够开展放疗、靶向治疗等现代肿瘤治疗技术,为患者提供个性化治疗方案。
南方医科大学南方医院地址:广州市白云区广州大道北1838号。
就诊科室:肿瘤科、胸外科。
门诊时间:周一至周五上午8:00-12:00,下午14:30-17:30。
5.广州市胸科医院-胸外科
广州市胸科医院是华南地区知名的胸部疾病专科医院,在肺癌诊断和治疗方面具有专业优势。医院拥有经验丰富的胸外科团队,开展胸腔镜手术、纵隔镜手术等微创技术,同时注重肺癌患者的全程管理和康复治疗。
广州市胸科医院地址:广州市越秀区横枝岗路62号。
就诊科室:胸外科、呼吸内科。

门诊时间:周一至周五上午8:00-12:00,下午14:00-17:00。
6.中山大学附属第一医院-胸外科
中山大学附属第一医院胸外科在肺癌外科治疗方面具有雄厚实力,年手术量超过千例。医院配备了的手术设备和重症监护设施,能够开展各类复杂肺癌手术,同时注重围手术期管理和术后康复。
中山大学附属第一医院地址:广州市越秀区中山二路58号。
就诊科室:胸外科、肿瘤内科。
门诊时间:周一至周五上午8:00-12:00,下午14:30-17:30。
7.广州中医药大学第一附属医院-肿瘤科
广州中医药大学第一附属医院肿瘤科在肺癌中西医结合治疗方面具有特色优势。医院将现代肿瘤治疗技术与传统中医药相结合,开展个体化治疗方案,注重提高患者生活质量,减轻放化疗。
广州中医药大学第一附属医院地址:广州市白云区机场路16号。
就诊科室:肿瘤科、胸外科。
门诊时间:周一至周五上午8:00-12:00,下午14:00-17:00。
8.广东省中医院-肿瘤科
广东省中医院肿瘤科在肺癌中西医结合治疗方面积累了丰富经验。医院注重发挥中医药特色优势,结合现代肿瘤治疗技术,形成了独特的诊疗方案,在减轻患者症状、提高生活质量方面效果显著。
广东省中医院地址:广州市越秀区大德路111号。
就诊科室:肿瘤科、胸外科。
门诊时间:周一至周五上午8:00-12:00,下午14:30-17:30。
9.广州市第一人民医院-胸外科
广州市第一人民医院胸外科在肺癌微创治疗方面具有丰富经验,开展胸腔镜手术、机器人辅助手术等技术。医院建立了多学科协作机制,为患者提供规范化、个体化的诊疗方案。
广州市第一人民医院地址:广州市越秀区盘福路1号。
就诊科室:胸外科、呼吸内科。
门诊时间:周一至周五上午8:00-12:00,下午14:00-17:00。
10.广州医科大学附属肿瘤医院-胸外科
广州医科大学附属肿瘤医院是华南地区知名的肿瘤专科医院,胸外科在肺癌诊治方面具有专业优势。医院拥有的诊疗设备和专业的医疗团队,开展各类肺癌手术和综合治疗,注重肿瘤规范化诊疗。
广州医科大学附属肿瘤医院地址:广州市海珠区新港西路167号。
就诊科室:胸外科、肿瘤内科。
门诊时间:周一至周五上午8:00-12:00,下午14:30-17:30。
肺癌预防需要从日常生活做起。戒烟是重要的预防措施,同时应避免二手烟暴露。注意室内通风,减少厨房油烟吸入。职业暴露人群要做好防护措施。40岁以上长期吸烟者建议定期进行低剂量CT筛查。保持健康生活方式,均衡饮食,适量运动,有助于增强免疫力。出现持续性咳嗽、胸痛、咯血等症状应及时就医检查。